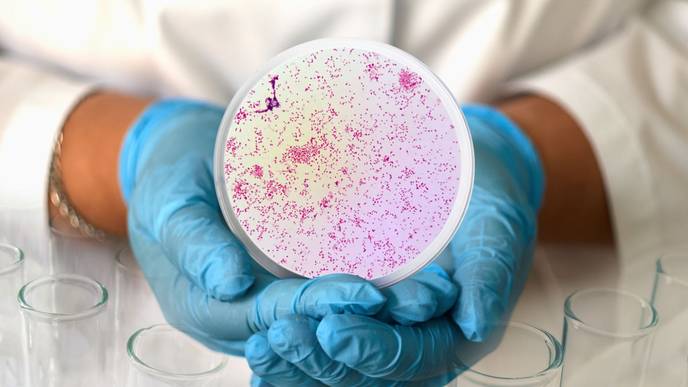

Protecting men who have sex with men against gonorrhoea with the 4CMenB meningococcal B vaccine is cost effective, Imperial College London study finds
Gonorrhoea is a sexually transmitted disease which is caused by infection with the Neisseria gonorrhoeae bacterium. Previous studies showed that the 4CMenB meningococcal vaccine (also called Bexsero®) partially protects against gonorrhoea.
This mathematical modelling study by Imperial College London, published in The Journal of Infectious Diseases, combines data on disease transmission and economics to evaluate the cost-effectiveness of vaccinating men who have sex with men (MSM) with 4CMenB to protect against future gonorrhoea infection.
To be cost-effective vaccination has to offered to those who are particularly at risk of gonorrhoea. Offering vaccination to patients diagnosed with gonorrhoea to reduce their risk of getting another infection can prevent 57,000 cases over 10 years and is cost-effective. Expanding the eligible group to include not only those with current infection but also uninfected individuals attending sexual health clinics who report more than five sexual partners per year is even more cost-effective. This approach could prevent 140,000 gonorrhoea cases over 10 years.
We have a gonorrhoea epidemic at present and offering the 4CMenB vaccine to at-risk men who have sex with men could greatly reduce the number of cases.Dariya NikitinStudy author
This study also examined the importance of variation in the population regarding how people feel about vaccination because this affects how many people ultimately get protected. In an “optimistic” scenario the number of gonorrhoea cases prevented is 30%-60% more than in a “pessimistic” scenario.
The authors demonstrate that a vaccination programme using 4CMenB does not need to achieve a minimum level of uptake to be cost-effective, although promoting vaccine uptake can increase the impact and value of the programme.
The UK’s Joint Committee on Vaccination and Immunisation (JCVI) has advised using the 4CMenB vaccine to protect men who have sex with men against gonorrhoea, and the UK government is currently considering this advice.
Prof Peter White, MRC Centre for Global Infectious Disease Analysis, Imperial College London, said: “We have examined for the first time how variation in the way people feel about vaccination in the community of men who have sex with men would affect the impact and cost-effectiveness of using 4CMenB to protect against gonorrhoea and it amounts to tens of thousands of cases and millions of pounds over a decade. Currently we don’t have information so we recommend community engagement activities and studies to understand the range of views so that we can make vaccination as effective as possible.”
Dariya Nikitin, MRC Centre for Global Infectious Disease Analysis, Imperial College London, said: “We have a gonorrhoea epidemic at present and offering the 4CMenB vaccine to at-risk men who have sex with men could greatly reduce the number of cases. Vaccination would be cost-saving because reduced costs of managing gonorrhoea cases outweigh the costs of the vaccination programme.”